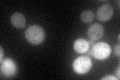
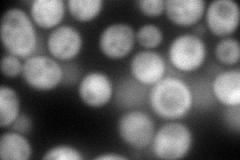
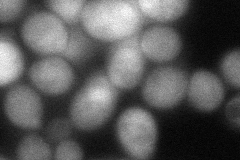
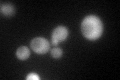

View description
Member of the heat shock protein 70 (HSP70) family; may be involved in protein folding; localized to the cytoplasm; highly homologous to the heat shock protein Sse1p
Localization:
Intensity:
Fold change:
Significance:
-
C’ GFP library in SD
cytosol50.57 -
N' NOP1pr-GFP in SD

cytosol210.816 -
N' TEF2pr-mCherry in SD
cytosol263.644 -
N' NATIVEpr-GFP in SD

cytosol51.3894 -
N' TEF2pr-VC and Cyto-VN in SD
cytosol78.2962 -
C’ GFP library in SD+DTT

cytosol107.742.13Yes -
C’ GFP library in SD+H2O2
cytosol79.471.57Yes -
C’ GFP library in Starvation Media

cytosol186.83.69Yes -
C’ GFP library on the background of Pup2-DaMP

cytosol -
C’ GFP library on the background of CCT mutant

cytosol59.29151.17234No
